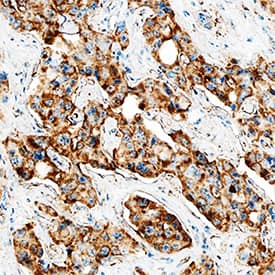
MMP-9 antibody in Human Liver Cancer Tissue by Immunohistochemistry (IHC-P).

Human MMP-9 Antibody
R&D Systems, part of Bio-Techne | Catalog # AB911

Key Product Details
Species Reactivity
Validated:
Cited:
Applications
Validated:
Cited:
Label
Antibody Source
Product Specifications
Immunogen
Specificity
Clonality
Host
Isotype
Scientific Data Images for Human MMP-9 Antibody
MMP‑9 in MMP‑9 transfected NS0 Mouse Cell Line.
MMP‑9 was detected in immersion fixed MMP-9 transfected NS0 mouse myeloma cell line using Goat Anti-Human MMP‑9 Polyclonal Antibody (Catalog # AB911) at 5 µg/mL for 3 hours at room temperature. Cells were stained (red) and counterstained (green). Specific labeling was localized to the cytoplasm. View our protocol for Fluorescent ICC Staining of Cells on Coverslips.MMP‑9 in Human Liver Cancer Tissue.
MMP-9 was detected in immersion fixed paraffin-embedded sections of human liver cancer tissue using Goat Anti-Human MMP-9 Polyclonal Antibody (Catalog # AB911) at 10 µg/mL overnight at 4 °C. Tissue was stained using the Anti-Goat HRP-DAB Cell & Tissue Staining Kit (brown; Catalog # CTS008) and counterstained with hematoxylin (blue). Specific staining was localized to cytoplasm in cancer cells. View our protocol for Chromogenic IHC Staining of Paraffin-embedded Tissue Sections.Detection of MMP-9 by Western Blot
Neutrophil degranulation is increased in response to C3d treatment. Neutrophils isolated from HC individuals were incubated at 37 °C and remained unstimulated (Con) or were stimulated with C3d (2–40 µg/mL) or TNF-alpha (10 ng / 2 × 107 cells) (A–C). (A) Cell-free supernatants were collected at 10 min and immunoblotted for markers of tertiary granule (MMP-9), secondary granule (hCAP-18), or primary granule (BPI) release. Densitometry of MMP-9 (B), hCAP-18 (C), and BLPI (D) immunobands was performed. Western blot analyses of whole cell lysates demonstrated equal expression levels of beta-actin, confirming the use of equal cell numbers per reaction. C3d-challenged neutrophils released significantly greater levels of all three granule types when compared to untreated controls (Con) (n = 5 biological repeats, ANOVA followed by Bonferroni post-hoc test for selected groups). All results are expressed as relative densitometry units (DU), with representative Western blots presented. Image collected and cropped by CiteAb from the following open publication (https://pubmed.ncbi.nlm.nih.gov/34944741), licensed under a CC-BY license. Not internally tested by R&D Systems.Applications for Human MMP-9 Antibody
Immunocytochemistry
Sample: Immersion fixed MMP‑9 transfected NS0 mouse myeloma cell line
Immunohistochemistry
Sample: Immersion fixed paraffin-embedded sections of human liver cancer tissue
Immunoprecipitation
Sample: Conditioned cell culture medium spiked with Recombinant Human MMP-9 (Catalog # 911-MP), see our available Western blot detection antibodies
Western Blot
Sample: Recombinant Human MMP-9 Western Blot Standard (Catalog # WBC018)
Formulation, Preparation, and Storage
Purification
Reconstitution
Formulation
Shipping
Stability & Storage
- 12 months from date of receipt, -20 to -70 °C as supplied.
- 1 month, 2 to 8 °C under sterile conditions after reconstitution.
- 6 months, -20 to -70 °C under sterile conditions after reconstitution.
Background: MMP-9
MMP-9 (Gelatinase B) is a metalloproteinase that degrades multiple extracellular matrix components including Gelatin, Collagens III, IV, V, and XI, Elastin, Nidogen-1, and Vitronectin. It also cleaves a variety of chemokines and growth factors (e.g. IL-1 beta, CXCL8/IL-8, CXCL7, CXCL4, CXCL1, Latent TGF-beta, membrane bound TNF-alpha, VEGF, and FGF basic), Amyloid beta peptide, Substance P, and Myelin Basic Protein. MMP-9 can trigger signaling through various transmembrane proteins or inhibit signaling by inducing their shedding from the cell surface (e.g. CD44, E-Cadherin, Integrins, ICAM-1, and CD25/IL-2 R alpha). The activity of MMP-9 is regulated by its association with the TIMP-1 protease inhibitor. Circulating levels of MMP-9 are elevated in many inflammatory disorders including intraluminal thrombus formation, atherosclerosis, Crohn’s disease, hepatitis C virus infection, colorectal cancer, and Duchenne muscular dystrophy.
Long Name
Alternate Names
Gene Symbol
Additional MMP-9 Products
Product Documents for Human MMP-9 Antibody
Product Specific Notices for Human MMP-9 Antibody
For research use only